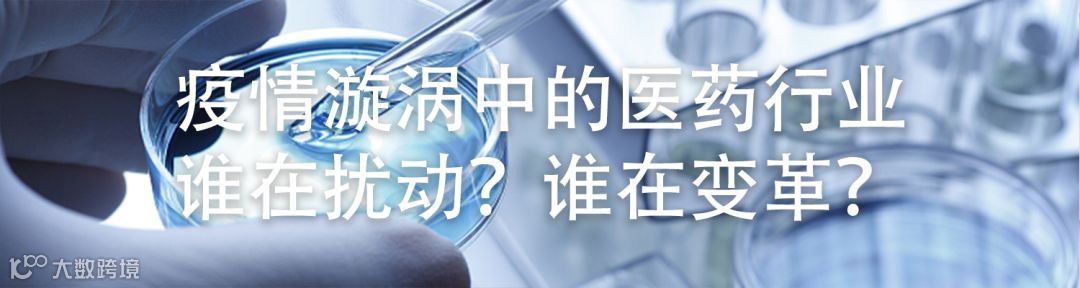

2020年的开年,一只又一只的“黑天鹅”腾空而起。
澳洲大火、美伊对决、新冠疫情、非洲蝗灾……每一年我们都在感慨世事无常,但应该从未想到这个新十年的开局会如此魔幻。
“黑天鹅”接连扇动翅膀,我们的投资是否只能“坐以待毙”?又或者可以转危为安,甚至抟扶摇羊角而上?
『本文对历史上的“黑天鹅”事件进行了细致回顾,通过总结黑天鹅的六大特点,向投资者提出了“攻守兼备”的投资建议,以期帮助投资者抓住乌云背后的silver line,洗白那只“黑天鹅”』
01
『在金融领域,“黑天鹅”往往被用于形容那些很难被预测、发生概率极低、但又会对系统产生严重影响的事件。』
近些年,在全球经济疲软以及全球化进程加剧的大背景下,“黑天鹅”事件发生频率不断上升,影响范围不断加大,一只只“黑天鹅”对全球和部分地区的资产定价以及投资组合管理造成了深刻的影响。
我们以MSCI全球股票指数和上证指数的涨跌幅为基础,整理了1990年-2020年间全世界范围以及中国境内的重大的“黑天鹅”事件,包括亚洲股市崩盘、911事件、雷曼兄弟倒闭、2003年中国的SARS、2015年中国的股灾等。
『结果发现,当“黑天鹅”事件发生时,股票市场的收益通常显著为负,而当“黑天鹅”事件结束后,股票市场在后续的很长一段时间都会有明显的上涨。』
1990-2020年间全球主要的“黑天鹅”事件

资料来源:国泰君安证券研究
因此我们开始重新审视,黑天鹅是不是真的只有黑历史,并通过总结大量资本界和学界的研究,由表及里梳理出了黑天鹅的六大特点。
02
1 特点一:“黑天鹅”的发生难以预测
目前关于“黑天鹅”的研究并没有一种可靠的模型能对“黑天鹅”进行预测,或能够准确测量“黑天鹅”对各类资产价格的影响。
这其中的原因可能有两方面。
一是由于“黑天鹅”的范围过于广泛,包括政治事件如苏联解体、恐怖事件如911、能源危机如OPEC停产、系统性违约事件如俄罗斯债券违约等,这让定量分析变得非常困难。
另一方面则是由于投资者的非理性在“黑天鹅”发生时会格外突出,从而对市场产生巨大扰动,让“黑天鹅”对资本市场的影响变得更加难以预测。
2 特点二:市场表现上,“黑天鹅”的开始和进行通常伴随着市场的下跌,结束时伴随着市场的上涨。
理论上说,由于“黑天鹅”通常为非预测性的外生性冲击,因此当“黑天鹅”开始并进行时,股票市场通常会受到三方面的负面冲击。
一是“黑天鹅”通常会导致股票基本面的恶化,从而影响公司的预期现金流,或因为风险加大而提升折现率,从而压制股票价格。
二是“黑天鹅”通常会引起投资者风险偏好的下降,抛售风险资产,驱动资金向避险资产流入,从而导致股票价格的下跌。
三是“黑天鹅”发生时经常伴随着市场的流动性下降,从而对股价不利。
『而当“黑天鹅”结束时,资产的基本面预期将改善,市场情绪恢复,投资者的风险偏好上升,从而驱动股票价格的上涨。』
通过研究历史上的全球风险事件,有学者对“黑天鹅”进程的三阶段分别做了年化计算,即:
当“黑天鹅”开始时,会导致全球股票市场约5%的下跌;
当“黑天鹅”进行时,全球股票市场会有约2%的下跌;
当“黑天鹅”结束时,全球股票市场则会迎来约3.5%的上涨。
这也与我们对1990-2020年间对“黑天鹅”事件的观察结论相一致。

数据来源:国泰君安证券研究
3 特点三:从波动率角度看,“黑天鹅”开始和进行时,股票市场波动率上升,结束时波动率下降。
当“黑天鹅”发生时,最显而易见的是其会加大经济以及资本市场后续的不确定性,从而导致市场的波动率上升,而当黑天鹅结束时,市场的不确定性减小,从而波动率下降。
4 特点四:从反应程度来看,“黑天鹅”对经济的影响越大,股票市场的反应越剧烈。
从金融常识来看,不同程度的“黑天鹅”对经济的影响有着显著的差别。从事实来看,2007-2008年的金融危机对经济的影响程度要显著的大于911事件,相应地,金融危机期间股票市场的下跌幅度和波动程度也显著的高于911事件。
5 特点五:“黑天鹅”发生期间,资产之间的相关性显著上升。
2008年金融危机之前,投资组合的风险主要通过资产类别的多样化来分散,但在2008年金融危机期间,投资者发现资产之间的相关性显著上升。
『这让大家逐渐认识到,投资组合的风险本质上并不简单的来源于资产类别,而实质上是来源于资产背后的风险因子。』
通过对不同资产内部以及资产之间的“黑天鹅”恐慌指数进行相关性检验,资本界和学界都发现“黑天鹅”风险因子的相关性非常高,即资产内部以及资产之间会受到“黑天鹅”风险的共同影响。

数据来源:JP Morgan,国泰君安证券研究
6 特点六:“黑天鹅”结束后,市场会有显著的超额收益,受“黑天鹅”影响越大的资产的预期收益越高,且该现象短期内不会消失。
同样根据“黑天鹅”的恐慌指数,学者发现“黑天鹅”时表现越差的资产,在后续的表现越好,且这一现象短期内不会消失。

03
通过对黑天鹅六大特征的总结,并结合海外机构应对“黑天鹅”的成功经验,我们认为可以从风险管理和把握投资机会两个角度,攻守兼备,不但做到减少“黑天鹅”的影响,甚至可以合理的抓住“黑天鹅”的投资机会。
风险管理
『在风险管理方面,将因子投资融入到资产配置、控制流动性和尾部风险是分散投资组合风险的可取之道。』
“黑天鹅”爆发时,资产的价格通常会迅速下跌,投资者会大量的抛售资产,从而导致市场流动性枯竭。
对于头部资管机构而言,系统全面的控制风险是投资管理的核心。
从2009-2018年全球头部机构的资产配置和投资表现来看,科学、系统的风险管理可以显著的降低投资组合的整体波动,提高投资组合风险调整后的收益。
我们以加拿大养老基金(CPPIB)为例。
CPPIB是最早也是最完整的将因子投资融入到整个投资管理流程中的头部机构。在控制投资组合长期风险水平的前提下,CPPIB通过因子投资将投资组合的整体风险分散化,显著提高了投资组合风险调整后的收益。
『如果以股票和另类资产的配置比例来衡量投资组合的风险水平,CPPIB过去10年债券的平均配置比例仅为28.44%,其风险水平显著的高于FRR、GPFG等养老基金。然而在过去的10年中,CPPIB业绩的波动率仅为4.21%,显著低于投资组合风险水平同样较高的养老金管理机构如CalPERS、NZSF、ATP等。』
此外,其他头部资管机构也都使用了一系列方法、指标以及对配置比例和投资标的的限制等,从绝对风险暴露、波动率、相关性风险、系统因子风险、流动性风险等不同的维度测量投资组合的整体风险,例如VaR、Expected Shortfall、跟踪误差波动率、压力测试等。

总体来看,08年的危机启示让资产管理的理论和实践发生了翻天覆地的变化。
主动出击,把握投资机会
对于把握投资机会,战略投资和战术投资的方法并不统一。
对于长期投资者,我们建议恪守再平衡策略,静候“黑天鹅”结束后资产收益的回归。
『理论上说,再平衡策略是一种典型的逆周期策略,其本质等同空波动率策略,由于资产价格长期具有均值回复的特征,因此再平衡具有显著的价值。』
而“黑天鹅”对资产价格的打压,为长期机构进行“再平衡”创造了绝佳的战术配置期。
历史上也不乏成功案例。
2007年,次贷危机爆发,权益类资产在组合中的权重急剧下跌。
在最黑暗的2007-2008年期间,GPFG恪守再平衡原则,大量的持续的购买权益类资产,同时调高了权益类资产在组合中的战略权重。
2009年,权益市场出现了大幅度反弹,受益于再平衡,GPFG当年获得了创纪录的25.6%的收益,抹平了金融危机期间的损失。

对于战术配置或短期投资者而言,他们往往更加关注投资策略的短期表现,因此可以考虑在“黑天鹅”发生期间配置受影响较小的资产或标的,在结束后配置受影响较大的资产或标的。
在“黑天鹅”发生并进行时,资产,特别是受“黑天鹅”影响较大的资产或标的往往会出现显著的下跌,而在黑天鹅结束和之后,这些资产或标的会有显著的超额收益。
『以2003年我国发生的SARS为例,2003年SARS期间劳动密集型的服务行业以及可选消费品受到的基本面冲击最大,市场下跌程度也最大,而医药行业则有所受益,股价涨幅处于市场前列。而当SARS缓和后,服务业以及消费品的基本面和股价也出现了显著的超跌反弹,而医药股则出现了“补跌”。』
2003年SARS对各个行业冲击的力度与其后续反弹力度成正比

04
最后我们将视线转回到2020年年初的这场“黑天鹅”——2019-nCov新冠疫情。
我们从病毒差异、发生时点、政府管控措施、经济动能、股票市场估值、经济的韧性多个维度综合比较此次新冠病毒和SARS对经济和股票市场影响的差异,虽然对资本市场的冲击目前看来相较2003年偏小,但对经济的后续影响不容忽视。
据此,我们分别对战略投资者和战术投资者提出了不同的投资建议。
长期投资者可在疫情开始和进行阶段进行再平衡策略,加大对权益资产的配置,适当的减少黄金、美元等避险资产的仓位;行业可以优先配置交运、零售和社服等受影响较大的行业。
『而在疫情结束以及之后,可以开始逐渐减少疫情期间相对表现较好的资产或标的。』
短期投资者可以选择的战术配置方案则是在疫情开始和进行阶段,优先选择避险类资产,例如黄金、日元、高等级债券;权益资产中可以优先选择医药等受影响较小的行业或标的。
『而在疫情结束以及之后,可以开始买入(卖出)疫情期间受影响最大(小)资产或标的,例如社服、交运和零售(以及黄金、日元、债券,权益中的医药类股票等)。』

◎以上内容节选自国泰君安证券已经发布的研究报告《如何将“黑天鹅”洗“白”》及公开资料,具体分析内容(包括风险提示等)请详见完整版报告。若因对报告的摘编产生歧义,应以完整版报告内容为准。
李少君(分析师) 证书编号 S0880517030001
蔡旻昊(分析师) 证书编号 S0880520010004
王鹤(研究助理) 证书编号 S0880119060069

《证券期货投资者适当性管理办法》于2017年7月1日起正式实施,通过微信订阅号发布的本图文消息仅面向国泰君安证券客户中的专业投资者。因本资料暂时无法设置访问限制,若您并非国泰君安证券客户中的专业投资者,为保证服务质量、控制投资风险,还请取消关注,请勿订阅、接收或使用本订阅号中的任何信息。我们对由此给您造成的不便表示诚挚歉意,非常感谢您的理解与配合!
免责声明:
以上内容仅代表作者个人观点,文中信息及所表述的意见仅供参考,在任何情况下,不构成对任何人的投资建议,国泰君安证券也不对任何人因使用本文内容所引致的任何损失负任何责任。投资有风险,入市需谨慎。
国泰君安证券订阅号(ID:GTJAOFFICIAL)为国泰君安证券股份有限公司(以下简称“国泰君安证券”)依法设立、独立运营的唯一官方订阅号,本订阅号所载内容版权仅为国泰君安证券所有,国泰君安证券对本订阅号保留一切法律权利,未经书面授权,任何媒体、机构、个人不得以任何形式转载、发表或引用。